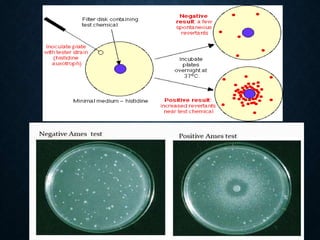

Genotoxicity refers to the ability of substances to damage genetic material like DNA. Genotoxicity testing aims to identify substances that may induce DNA damage through in vitro and in vivo assays. The Ames test is a widely used bacterial reverse mutation assay to assess mutagenicity. Mammalian cell assays like the micronucleus test and comet assay are also employed to study chromosomal damage and DNA breakage in vivo. Standard test batteries from organizations like OECD provide guidelines for various assays to thoroughly evaluate genotoxic potential of new chemicals and drugs. Genotoxic agents can cause cancer, mutations and birth defects by interacting with and damaging DNA.




















![PRE-INCUBATION METHOD
• Pre-incubated with the test strain .
• 0.05-0.1ml (approx. 108 cells) & sterile buffer or the
metabolic activation system (s9 0.5 ml) usually for 20 min
@30-37°c [aeration+ shaker – 48 to 72hrs]
• Mix overlay agar (2ml) and pouring onto the surface of a
minimal agar plate
• • Report number of revertant colonies per plate
• • ( with +ve & -ve coloies nos)
• • Standard deviation](https://image.slidesharecdn.com/genotoxicity-190423103249/85/Genotoxicity-21-320.jpg)